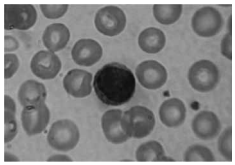
Enunciado 596975-1

Foram encontradas 50 questões.
Em relação ao exame que utiliza a coloração de
Ziehl-Neelsen, é correto afirmar:
Provas
Questão presente nas seguintes provas
O tubo e/ou tubo seringa contendo fluoreto de sódio e
EDTA (ácido etileno diamino tetra-acético), comercializados por fabricantes desse segmento (tampa de cor cinza)
e usados em coleta de sangue venoso, são recomendados para a determinação quantitativa de
Provas
Questão presente nas seguintes provas
O método de concentração por migração que possui
como princípios o hidrotropismo e o termotropismo e
que se utiliza para pesquisa de larva de Strongyloides
stercoralis em laboratórios clínicos é:
Provas
Questão presente nas seguintes provas
A contagem de hemácias realizada no exame de urina
tipo I ou sumário, quando acima do valor de referência,
na proporção de 10 ou mais vezes, geralmente possui
correlação direta com
Provas
Questão presente nas seguintes provas
Assinale a afirmativa correta referente a sistemas automatizados no processamento de exames bioquímicos.
Provas
Questão presente nas seguintes provas
Os parasitos encontrados no sangue e nos tecidos humanos pertencem a vários grupos, dentro de protozoários e
helmintos. O parasito que pode ser identificado, por meio
da análise microscópica de lâminas do sangue periférico
coradas, em técnica denominada gota espessa é:
Provas
Questão presente nas seguintes provas
Em relação à calibração de equipamentos em laboratórios clínicos, assinale a alternativa correta.
Provas
Questão presente nas seguintes provas
- Hematologia nas Técnicas em Laboratório
- Técnicas Manuais e Automatizadas de Aparelhos e Materiais, Para Fins de Diagnóstico Hematológico
Assinale a alternativa correta em relação à contagem de
plaquetas por hemocitometria, com auxílio de câmara de
Neubauer ou autoanalisadores hematológicos.
Provas
Questão presente nas seguintes provas
Os analitos que podem ser realizados pelos métodos
turbidimétrico, íon-seletivo e colorimétrico, respectivamente, são:
Provas
Questão presente nas seguintes provas
Analise o texto e a imagem a seguir, obtida em extensão corada e com auxílio de microscópio.
“Uma célula pequena de alta relação núcleo/citoplasma, núcleo redondo com cromatina condensada em grandes blocos, citoplasma escasso e basofílico”.
Trata-se de
Provas
Questão presente nas seguintes provas
Cadernos
Caderno Container